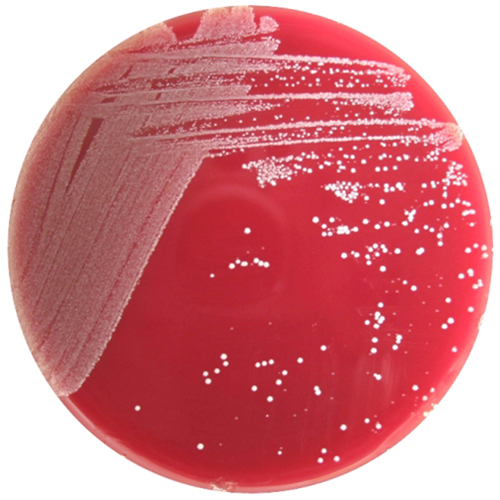
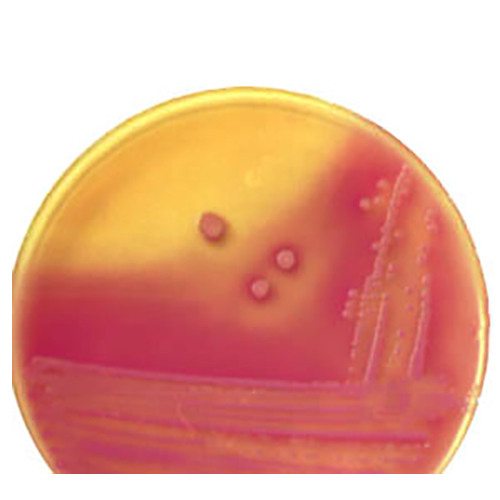
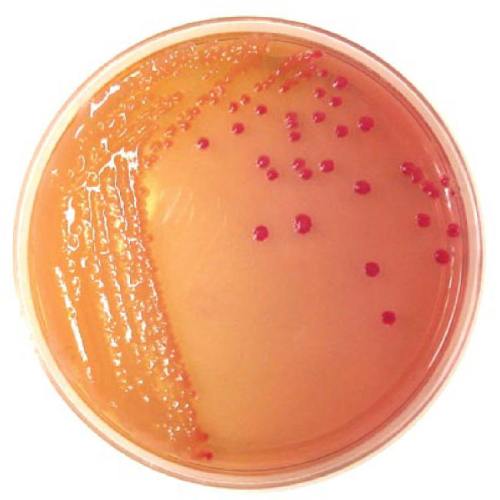
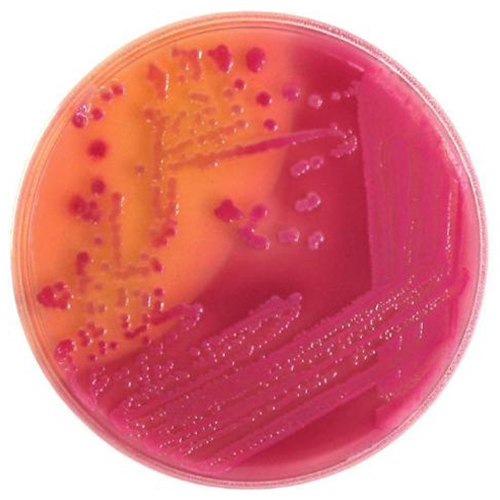
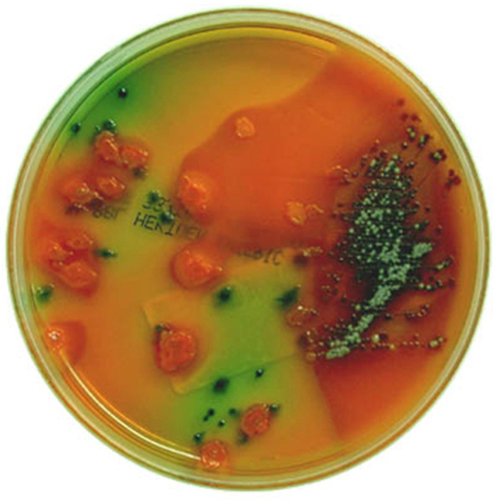
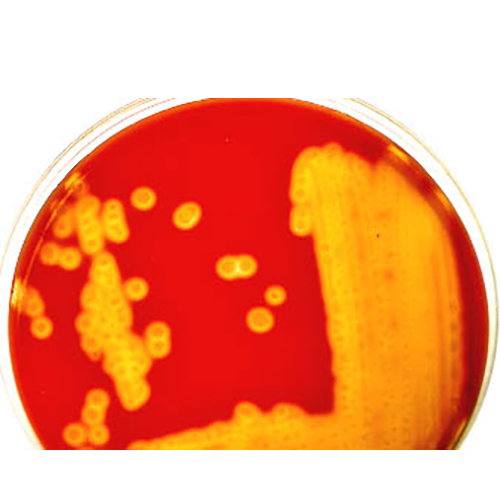
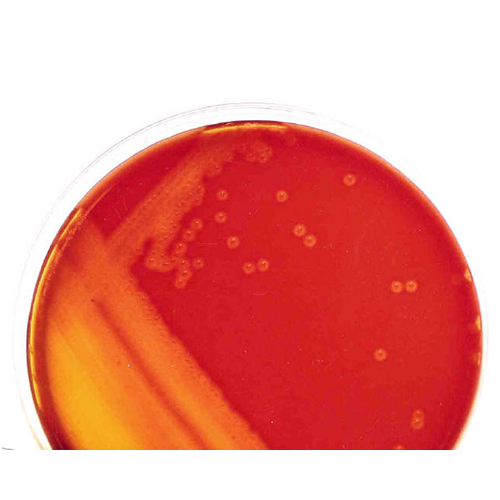
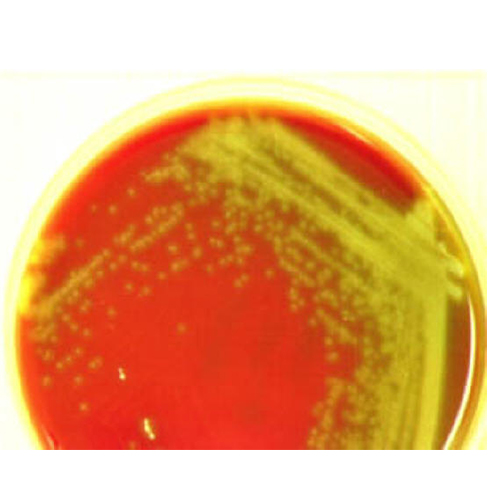
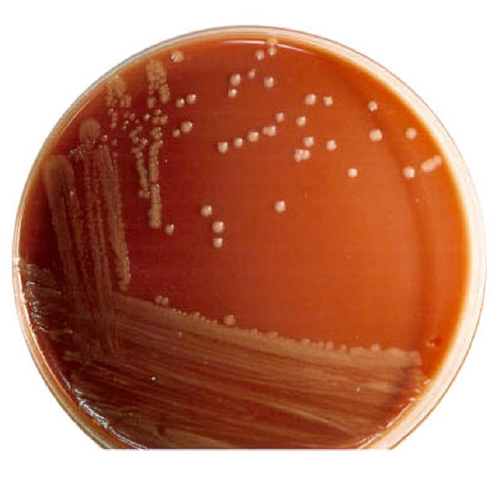
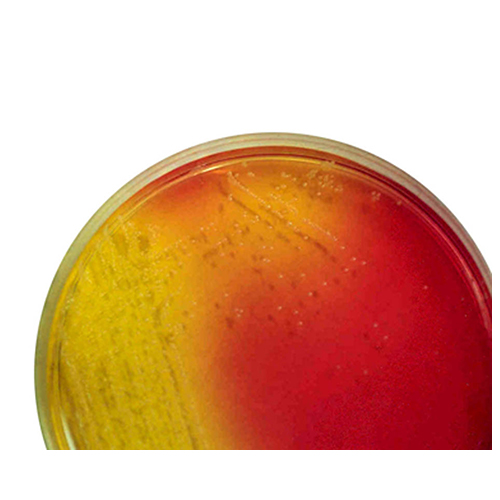
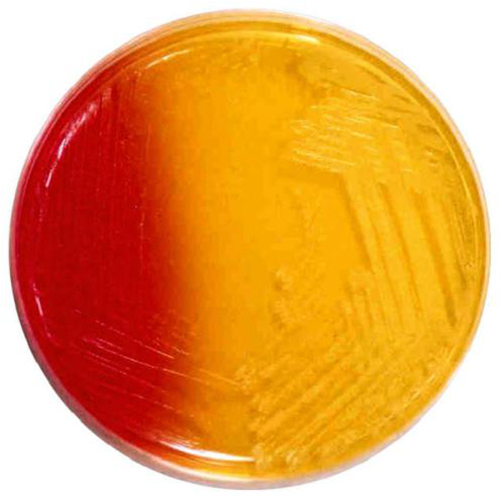
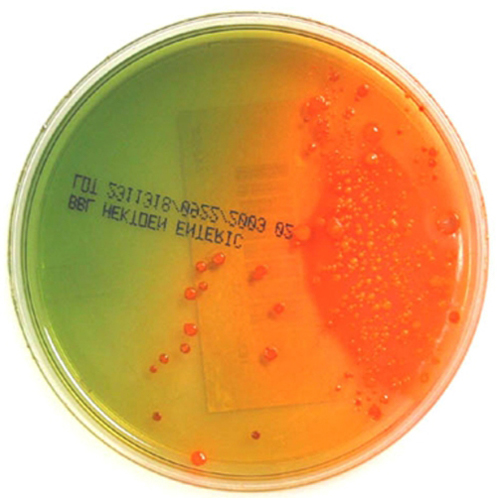
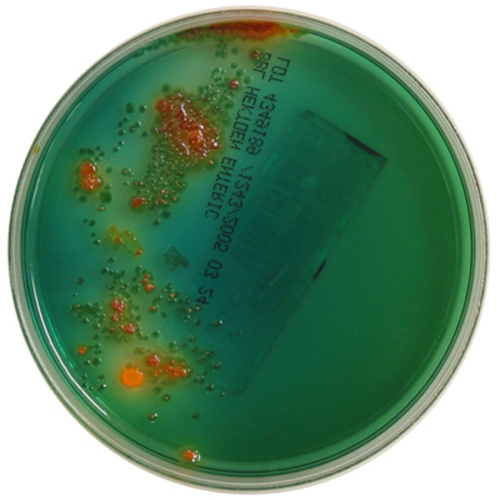

Primary Plating Media
Click on the thumbnails below to view the full sized images
PEA
1) 4+ white, 2) 4+ pinpoint
The white colony is a Gram pos cocci and the pinpoint colony is an enteric GNR. If you were to compare the PEA to the SBA, the white colony would look about the same on both plates. The pinpoint colony would appear as a large gray mucoid on the SBA. Note that a PEA plate is equal to a CNA plate except that the GNR would not grow at all.
PEA
MAC Lac. pos. Bile ptt.
2+ Lac pos, bile ppt (E. coli)
Note the bile ppt red haze coming from quad 1 and 2. This organism is capable of breaking down the lactose very quickly, causing a sharp drop in the pH, resulting in the bile salts falling out of solution and forming a red precipitate.
MAC Lac. pos. Bile ptt.
MAC Lac. pos.
2+ Lac pos (Enterobacter)
The lactose reaction should only be interpreted in the areas of the plate where the organism is isolated, such as in Quad 2 and 3. In this photo, there are areas where there is a high concentration of organism, such as Quad 1 and 2, where all of the lactose has been utilized, giving the appearance of lac neg organism. The yellow colonies in this concentrated area are due to the depletion of lactose and then the utilization of the peptones in the media, which raises the pH.
MAC Lac. pos.
MAC @ 48hrs.
4+ Lac pos, bile ppt @ 48 hrs
Note the yellow color that is forming after incubation for 48 hrs., just to the upper left center of the plate. This is due to the media drying out, which turns the neutral red dye yellow from the rise in pH. MAC plates should be interpreted at 24 hrs.
MAC @ 48hrs.
HEA Lac/suc neg possible pathogen
2+ lac/suc neg
The black colored colonies indicates a possible pathogen, perhaps Salmonella. Also note the salmon colored colonies from the lac/suc pos non-pathogenic GNR enteric flora. Note: there are also other non-pathogenic organisms that can produce black colonies on HEA, such as Citrobacter and Proteus.